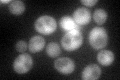
YER089C
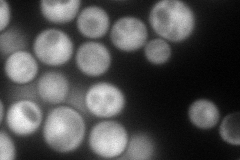
YER089C
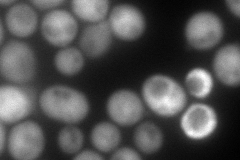
YER089C
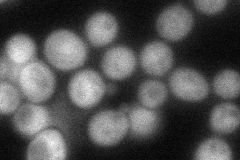
YER089C
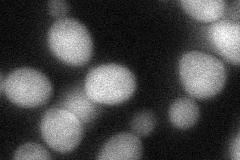
YER089C
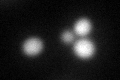
YER089C
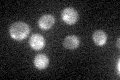
YER089C

View description
Type 2C protein phosphatase; dephosphorylates Hog1p to limit maximal osmostress induced kinase activity; dephosphorylates Ire1p to downregulate the unfolded protein response; dephosphorylates Cdc28p; role in DNA checkpoint inactivation
Localization:
Intensity:
Fold change:
Significance:
-
C’ GFP library in SD
nucleus:cytosol71.64 -
N' NOP1pr-GFP in SD
cytosol160.538 -
N' TEF2pr-mCherry in SD
cytosol223.391 -
N' NATIVEpr-GFP in SD
cytosol80.1098 -
N' TEF2pr-VC and Cyto-VN in SD
cytosol60.7044 -
C’ GFP library in SD+DTT
nucleus.cytosol53.230.74No -
C’ GFP library in SD+H2O2

nucleus.cytosol58.080.81No -
C’ GFP library in Starvation Media
nucleus,cytosol28.570.39Yes -
C’ GFP library on the background of Pup2-DaMP

nucleus:cytosol -
C’ GFP library on the background of CCT mutant

nucleus:cytosol70.9980.99096No
